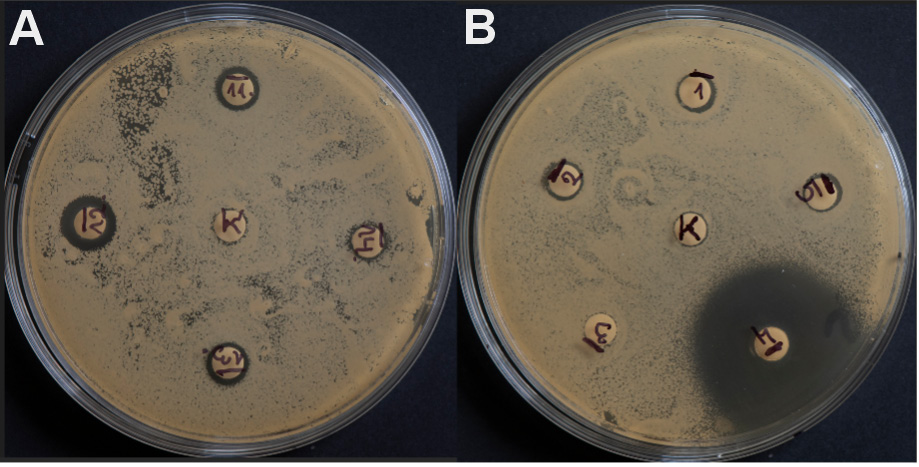
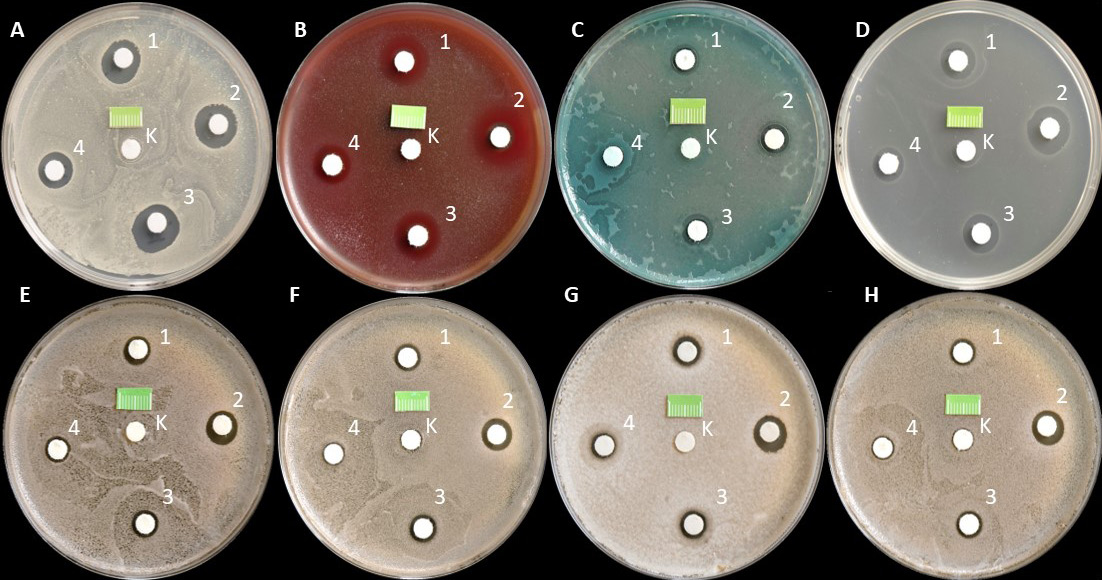
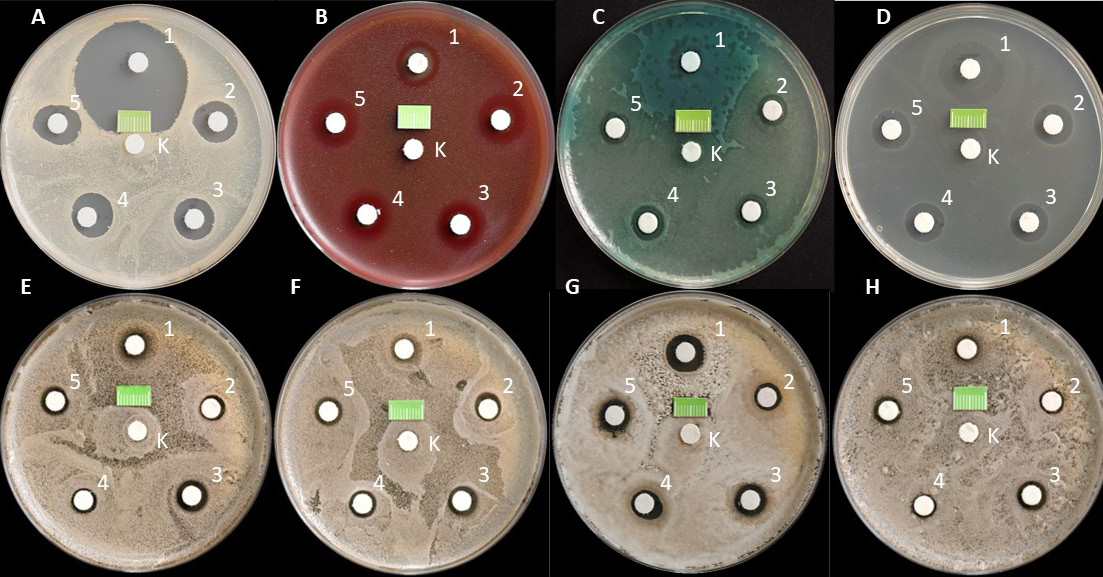

Abstract
Background. Chlorhexidine digluconate (CHG) is considered the most effective and safe antimicrobial agent in dentistry. Recently, it has often been produced in the form of preparations with additional substances that may modify its effect.
Objectives. The aim of the present study was to compare the efficacy of various simple and combined CHG rinses against selected bacterial and yeast strains.
Material and methods. This research followed the European Committee on Antimicrobial Susceptibility Testing (EUCAST) guidelines, using the disk diffusion method. The study was carried out on the following reference strains: Staphylococcus aureus ATCC 43300; Streptococcus pyogenes ATCC 19615; Pseudomonas aeruginosa ATCC 27853; Enterococcus faecalis ATCC 29212; Candida albicans ATCC 10231; C. glabrata ATCC 15126; C. krusei ATCC 14243; and C. parapsilosis ATCC 22019. The disinfection efficacy of 9 commercial mouthwashes with CHG was assessed (4 simple preparations, with different concentrations (0.5%, 0.2%, 0.12%, and 0.05%), and 5 combined preparations (0.2% CHG with adjuvants)) by comparing the size of the growth inhibition zones (GIZs) of microorganisms after 24 h of incubation.
Results. Growth inhibition zones were observed around all tested substances, for all assessed strains. In simple preparations, the greatest reduction in growth was observed for Gram-positive bacteria. Statistically significantly smaller GIZs were recorded for P. aeruginosa and all Candida strains. The size of GIZ also depended on the CHG concentration used. In combined preparations, the greatest reduction in growth was also observed for Gram-positive bacteria (especially large GIZs for S. aureus when using 0.2% CHG with colostrum). Statistically significantly smaller GIZs were observed for P. aeruginosa and all yeasts. None of the evaluated adjuvants impaired the disinfecting effect of CHG.
Conclusions. The evaluated combined preparations of CHG showed disinfecting efficacy against selected bacterial and fungal strains comparable to that of simple formulations. The combination of 0.2% CHG with colostrum showed the additive synergism of antimicrobial activity against the S. aureus ATCC 43300 strain.
Keywords: chlorhexidine, mouthwash, infection control, mouth rinse, antiseptic
Introduction
Chlorhexidine (CHX) is an organic chemical compound, a biguanide derivative, which serves as a synthetic antiseptic. Pharmacologically, it mostly occurs in the form of digluconate, diacetate or dihydrochloride salt. The most often used disinfectant is chlorhexidine digluconate (CHG).1
The antibacterial spectrum of CHG is broad, and covers both vegetative forms of Gram-positive and Gram-negative bacteria, some viruses (herpes virus, human immunodeficiency virus (HIV), influenza virus, and cytomegalovirus (CMV)), and yeasts as well as dermatophytes.2, 3, 4 However, it does not act on bacterial spores at room temperature and on some small viruses (papillomavirus, enterovirus and poliovirus).5
Depending on the CHG concentration used and the environmental factors (pH, the temperature and the exposition time), the mechanism of action of this compound varies from bacteriostatic to bactericidal. A cation molecule of CHG is attracted to the negatively charged surface of the microbial cell. Afterward, it connects with the bacterial membrane (phosphate and 2-keto-deoxy-caprylic groups in lipopolysaccharides, and carboxyl groups in proteins), thereby changing its integrity. That leads to increased cell membrane permeability and the loss of low-mass molecules (mainly potassium ions – K+), and inhibits the activity of some membrane enzymes. It is a reversible mechanism of CHG at a bacteriostatic stage. Increasing the concentration of CHG leads to greater damage to the cell membrane, resulting in the loss of cellular components, such as nucleic acids. The effects of the substance become irreversible with the loss of approx. 15% of nucleotides. Cytoplasmic elements are also precipitated by forming complexes with phosphorylated compounds, e.g., adenosine triphosphate (ATP). Chlorhexidine digluconate can be chemisorbed onto the hydroxyapatite surface or may interact as an ion, forming non-resorbable compounds with phosphates in the mouth, hydroxyapatite, dental plaque, and the carboxyl groups in collagen found in dentin and the connective tissue. These bonded compounds can gradually release CHG over time, prolonging its antimicrobial effect (even up to 12 h), which negatively impacts the possibility of forming biofilm by bacteria and fungi.5, 6, 7
The oral cavity is the initial segment for both the digestive tract and the respiratory system, and it is a reservoir for numerous microorganisms. Oral microbiome includes bacteria such as streptococci, staphylococci, bacteria of the genera Lactobacillus, Neisseria, Prevotella, Porphyromonas, Veillonella, Actinomyces, and many others.8, 9, 10 Among the fungi, the predominate yeast species are Candida albicans, C. dubliniensis and C. glabrata.11, 12 When the body balance is disturbed, those organisms may transform into pathological flora.
Streptococci are responsible for the inflammation of the throat and tonsillitis, while Staphylococcus aureus is very often isolated in the inflammation of the labial commissures and skin (contagious impetigo). In the etiology of this disease, also Streptococcus pyogenes and Pseudomonas aeruginosa should be considered.13 Yeast infections are most common in the oral cavities of immunocompromised patients.14, 15, 16 Controlling such inflammation is an extremely important element of successful dental treatment. Antiseptics exhibiting a broad antimicrobial spectrum are used for this purpose, of which CHG is one of the most popular. Inflammation is manifested clinically as edema, bleeding, pain, damage to the epithelium of the oral mucosa, and difficulties in food intake and hygiene maintenance.17, 18, 19 That is why there are various types of combined preparations, which contain CHG in different concentrations, as well as additional active ingredients exhibiting anti-inflammatory, analgesic, local anesthetic, and coating properties, along with accelerating tissue healing, sealing blood vessels and strengthening natural immune mechanisms. Such commercial products are dedicated to the complex, one-step treatment of the oral cavity, causative (the elimination of the etiological microbial flora) and symptomatic.
The issues studied so far include the sensitivity of microorganisms to various concentrations of CHG,20, 21, 22, 23, 24 the disinfecting efficacy of CHG in comparison with other oral disinfectants (e.g. Listerine®, essential oils, cetylpyridinium chloride (CPC))25, 26, 27, 28 or the combination of CHG with other substances with antimicrobial activity but different mechanisms of action, e.g., CHG with CPC, colloidal solutions containing nanoparticles, hydrogen peroxide, or essential oils.29, 30, 31, 32, 33 However, there is a lack of studies that would unambiguously show the mechanism of action of CHG combined with adjuvants with an anti-symptomatic effect (additive/super-additive synergism or competence/functional/chemical antagonism). Therefore, the purpose of the present study was to compare the efficacy of various simple and combined CHG rinses against selected bacterial and yeast strains.
Material and methods
Organisms and growth conditions
This research followed the European Committee for Antimicrobial Susceptibility Testing (EUCAST) guidelines (v. 9.0, January 2019), using the disk diffusion method.34
The study was carried out on 4 reference strains of bacteria: Staphylococcus aureus ATCC 43300; Streptococcus pyogenes ATCC 19615; Pseudomonas aeruginosa ATCC 27853; and Enterococcus faecalis ATCC 29212, which are frequently detected in the classic form of impetigo lesions of red lips and corners of the mouth (angular cheilitis).11, 13 Besides, the 4 most common species causing oral candidiasis were used in the experiment, namely Candida albicans ATCC 10231, C. glabrata ATCC 15126, C. krusei ATCC 14243, and C. parapsilosis ATCC 22019.11, 12 The species were taken from the American Type Culture Collection (ATCC, Manassas, USA); they belong to the strain bank of the Department of Microbiology and Virology, Faculty of Pharmaceutical Sciences in Sosnowiec, Medical University of Silesia, Katowice, Poland. They were stored at −80°C in tryptic soy broth with the addition of glycerol.
The cultures of each species were placed separately on a Petri dish of a 90-millimeter diameter, with agar supplemented with 5% defibrinated sheep blood (bioMérieux, Marcy-l’Étoile, France), 4 mm deep (approx. 25 mL). The agar surface was dry and homogeneous. After 24 h of incubation at 37°C in aerobic conditions, a sample of colonies was removed from the surface of the plate and suspended in a sterile saline solution (0.9% NaCl; B. Braun, Melsungen, Germany). The number of viable cells in the suspension was counted using a Densi-La-Meter II densitometer (Erba Lachema, Prague, Czech Republic) at a wavelength of 525 nm. We used an optical density of McFarland of 0.5, which corresponds to approx. 1.2 × 108 CFU (colony-forming units)/mL for bacteria and 1.5 × 106 CFU/mL for yeasts.
Then, 15 min after preparation, 1 mL of the prepared Candida spp. suspension (for each strain separately) was inoculated with a sterile pipette onto the surface of Sabouraud dextrose agar (SDA) with chloramphenicol (bioMérieux). The suspensions of the S. aureus, P. aeruginosa and E. faecalis species were inoculated on the surface of the Mueller–Hinton agar (MHA) (bioMérieux), and the suspension of the S. pyogenes strain on the surface of the Mueller–Hinton agar enriched with 5% defibrinated sheep blood (MHF) (bioMérieux). A total of 48 plates were prepared, 6 for each tested strain.
The plates were marked with numbers I–VIII, as follows:
I. S. aureus ATCC 43300;
II. S. pyogenes ATCC 19615;
III. P. aeruginosa ATCC 27853;
IV. E. faecalis ATCC 29212;
V. C. albicans ATCC 10231;
VI. C. glabrata ATCC 15126;
VII. C. krusei ATCC 14243;
VIII. C. parapsilosis ATCC 22019.
Materials and analyzed substances
In total, 264 sterile paper disks (Oxoid™ blank antimicrobial susceptibility disks; Oxoid Ltd., Basingstoke, UK), 6 mm in diameter, were prepared for the study. According to the previously prepared templates, 33 disks were assigned for each tested strain, 5 or 6 per plate.
Study and control groups
The test groups were comprised of the disks located on the periphery of the plates. They were soaked in 9 tested preparations – oral hygiene solutions from Curasept (Saronno, Italy) (Figure 1) – by applying 20 µL of each liquid to appropriate disks.
To blind the trial, this part of the experiment was only performed by a microbiologist unfamiliar with the assessed preparations. The test tubes with the analyzed substances were marked with the following numbers (Figure 1):
1. 0.2% CHG solution;
2. 0.5% CHG solution;
3. 0.12% CHG solution;
4. 0.05% CHG solution;
5. a liquid containing 0.2% CHG solution + colostrum + polyvinylpyrrolidone/vinyl acetate (PVP/VA) copolymer;
6. a liquid containing 0.2% CHG solution + chlorobutanol (ChB);
7. a liquid containing 0.2% CHG solution + hyaluronic acid (HA);
8. a liquid containing 0.2% CHG solution + Hamamelis; and
9. a liquid containing 0.2% CHG solution + HA + phyto DNA.
Liquids 1–4, containing only CHG at various concentrations, were placed on the plates with 5 disks, while fluids 5–9, containing 0.2% CHG solution with various assessed additives, were placed on the plates with 6 disks. The control (marked with the letter K) was a paper disk soaked in 20 µL of sterile saline (0.9% NaCl), placed in the center of the plate, regardless of the reference used (Figure 2).
The maximum number of disks on a 90-millmeter plate was 6. This number of disks prevents the possible overlapping of growth inhibition zones (GIZs) after incubation. In addition, the distances between the disks, following the EUCAST guidelines, were ≥20 mm, which meant that the individual preparations did not affect each other. All disks were placed on the plates within 15 min of inoculation. A sterile 1-centimeter fragment of the ruler scale was also placed in a specific place in each dish to assess the diameter of GIZ based on the photographic documentation taken for the test.
The cultures were incubated at 35 ±2°C under aerobic conditions in a MIR-262 laboratory incubator (Sanyo E&E Europe, Etten-Leur, the Netherlands). The experiment for each strain was performed in triplicate (Figure 3).
After 24 h of incubation, the Petri dishes were removed from the incubator and photographed with a DMC-G80 Lumix camera (Panasonic, Osaka, Japan) equipped with a Lumix H-FS12060 12–60-millimeter micro HD lens (Panasonic) from a fixed distance of 30 cm at an angle of 90° to the surface. The camera was mounted on a tripod (Figure 4).
The diameters of GIZs around individual disks were read after collecting all planned photos. The analysis was performed using the ImageJ – Fiji, v. 1.53j (National Institutes of Health (NIH), Bethesda, USA) software platforms. The measurement was carried out after calibrating the size from the left to the right border of GIZ parallel to the base of the photo so that the line passed through the center of the diffusion disk. The diameters were provided in millimeters. The obtained results were saved in an Excel spreadsheet (Microsoft, Redmond, USA), and then subjected to statistical evaluation.
Statistical analysis
The results were presented as mean and standard deviation (M ±SD). Statistical differences were assessed using the analysis of variance (ANOVA) and the Newman–Keuls post-hoc test. A p-value ≤0.05 was considered to indicate a statistically significant difference.
The statistical analysis was performed using Statistica, v. 7.1 PL (StatSoft Poland, Krakow, Poland).
Results
The research results obtained in the first part of the experiment illustrate the effect of the preparations containing only CHG, at various concentrations, on the growth of selected reference bacteria and fungi as compared to the control sterile saline (0.9% NaCl). In the case of all tested strains, a homogeneous, confluent (uncountable) increase in CFU was observed on the surface of the media in Petri dishes after 24 h of incubation (Figure 5). In the present study, undisturbed microbial growth around all central paper disks (control) was particularly visible. A completely different pattern was observed around the paper disks soaked in 0.2%, 0.5%, 0.12%, and 0.05% CHG solutions. For all tested strains, clear GIZs were observed after 24 h of incubation. However, these zones had different sizes.
Among bacteria, the highest average value of zone diameter, obtained from 3 measurements, was recorded for 0.5% CHG solution for the S. pyogenes ATCC 19615 strain, amounting to 17.81 mm. The following places were taken by S. aureus ATCC 43300 – 15.25 mm, E. faecalis ATCC 29212 – 13.48 mm and P. aeruginosa ATCC 27853 – 9.34 mm. These results were statistically significantly higher than those obtained for other concentrations (p < 0.001) There were no statistically significant differences between the concentrations of 0.2% and 0.12% for individual bacterial strains (p > 0.05). The lowest results were obtained for 0.05% CHG solution: S. pyogenes ATCC 19615 – 12.24 mm; S. aureus ATCC 43300 – 10.83 mm; E. faecalis ATCC 29212 – 10.33 mm; and P. aeruginosa ATCC 27853 – 7.23 mm. The latter result was statistically significantly different in comparison with the control (6 mm – the width of the diffusion disk itself) (p < 0.001) (Table 1, Figure 6).
Statistically significant differences were noted in the effect of individual simple CHG rinses on the assessed bacterial strains. They were most effective against S. pyogenes ATCC 19615 (p < 0.001), followed by S. aureus ATCC 43300 (p < 0.001), E. faecalis ATCC 29212 (p < 0.001) and P. aeruginosa ATCC 27853 (p < 0.01) (Figure 6).
Among yeasts, the highest average value of zone diameter, obtained from 3 measurements, was recorded for 0.5% CHG solution for the C. albicans ATCC 10231 strain, and it was 10.86 mm. The following places were taken by C. krusei ATCC 14243 – 10.59 mm, C. glabrata ATCC 15126 – 10.43 mm and C. parapsilosis ATCC 22019 – 10.24 mm. These results were statistically significantly higher than those obtained for other concentrations (p < 0.001). No statistically significant differences were noted between the concentrations of 0.2% and 0.12% for individual Candida strains (p > 0.05). The lowest result for yeasts of 7.22 mm was recorded for the C. parapsilosis ATCC 22019 strain for 0.05% CHG solution, which was statistically significantly different in comparison with the control (p < 0.01) (Table 2, Figure 7).
However, there were no statistically significant differences in the effect of individual simple mouth rinses on the assessed Candida strains (Figure 7).
The research results obtained in the second part of the experiment illustrate the effect of various commercial combined preparations with a fixed 0.2% CHG solution together with bovine colostrum, ChB, HA, Hamamelis extract, and HA with fragments of DNA obtained from plant sources on the growth of selected reference bacteria and yeasts as compared to the negative control (C−), saline. Furthermore, in the statistical analysis of this part of the study, the positive control (C+) was used, which was 0.2% CHG solution taken from the first part of the study (Figure 8).
In all tested strains, after 24 h of incubation, a uniform, confluent (uncountable) increase in CFU was observed on the surface of the media in Petri dishes. Undisturbed colony growth was observed around all the central paper disks constituting the study controls. A different picture was observed around the paper disks soaked in the evaluated combined CHG solutions. For all tested strains, clear GIZs were observed after 24 h. These zones had significantly different sizes.
Among bacteria, the highest average value of zone diameter, obtained from 3 measurements, was recorded for 0.2% CHG + colostrum for the S. aureus ATCC 43300 strain, amounting to 33.06 mm. This result was statistically significantly higher as compared to the results obtained for other bacteria (p < 0.001).
Significant GIZs were also recorded for S. pyogenes ATCC 19615. Depending on the substance added, the values ranged from 16.47 mm for 0.2% CHG + Hamamelis to 14.86 mm for 0.2% CHG + colostrum. For the E. faecalis ATCC 29212 strain, slight differences in the size of GIZs were noted, with the best result of 12.42 mm for 0.2% CHG + HA, and the worst result (11.60 mm) for 0.2% CHG + colostrum. The results for all assessed solutions were statistically significantly different, and also significantly different in comparison with the control (p < 0.001). The smallest diameters of GIZs were recorded for P. aeruginosa ATCC 27853, for which the lowest result of 7.42 mm was read for the 0.2% CHG + colostrum regimen. This result was statistically significantly different in comparison with the control (p < 0.01) (Table 3, Figure 9).
Statistically significant differences were noted in the effect of individual combined CHG rinses on the assessed bacterial strains. They were most effective against S. pyogenes ATCC 19615, followed by S. aureus ATCC 43300, E. faecalis ATCC 29212 and P. aeruginosa ATCC 27853 (Figure 9).
Among yeasts, the highest average value of zone diameter, obtained from 3 measurements, was recorded for 0.2% CHG + colostrum for the C. krusei ATCC 14243 strain, and it was 12.56 mm. The following places were taken by C. albicans ATCC 10231 – 9.86 mm for 0.2% CHG + HA, C. parapsilosis ATCC 22019 – 9.81 mm for 0.2% CHG + HA + DNA and C. glabrata ATCC 15126 – 9.74 mm for 0.2% CHG + HA. These results were statistically significantly different from those obtained for the negative control (p < 0.001), but not significantly different from those obtained for the positive control (p > 0.05) (Table 4, Figure 10).
Discussion
This study aimed to compare the efficacy of different simple and combined CHX mouthwashes against selected bacterial and yeast strains. The study was designed to include reference strains representing microorganisms commonly inducing frequent infections, like oral candidiasis (Candida spp.),11, 12, 14 impetigo, angina (S. aureus, S. pyogenes, P. aeruginosa),13 and endodontic infections (E. faecalis).35 The treatment of these infections involves the usage of antiseptics, especially CHG. Furthermore, the selected strains represented microorganisms exhibiting variable morphological and physiological features. Three microorganisms, i.e., S. aureus, S. pyogenes and E. faecalis, are Gram-positive bacteria, and the other one – P. aeruginosa – is a Gram-negative bacterium. The cells of those microbes differ in terms of the thickness, structure and composition of the cell wall, as well as the presence of the polysaccharide coating.36 The presence of a very thick, mucous alginate coating in P. aeruginosa is associated with, among others, particularly large resistance to disinfectants and antibiotics.37 The environmental conditions of the selected bacteria are also distinct, specifically the demands regarding nutrients and oxygen. Staphylococci (S. aureus), streptococci (S. pyogenes) and enterococci (E. faecalis) are facultative anaerobes. On the other hand, the metabolism of P. aeruginosa is strictly aerobic. The microorganisms used in the research also differed significantly in cell size. Yeasts are 25–50 times bigger than bacteria. They belong to eukaryotes and have a more complex structure.36 Their cells have a distinctly formed nucleus surrounded by a nuclear membrane and numerous cell organelles. Candida cells are surrounded by a thick, hardly permeable cell wall composed of beta-glucan, mannoproteins and chitin. The abovementioned differences between the organisms were intended to ensure the comprehensiveness of the observations and their future clinical usefulness.
Moreover, the experiment was planned to be carried out in stages. The first part assessed simple preparations in a liquid formula, at various CHG concentrations. In addition, the most common CHG concentrations in commercial and dental preparations were compared, i.e., 0.05%, 0.12%, 0.2%, and 0.5%. The selected products were obtained from a European manufacturer with the broadest portfolio. The results obtained in this phase confirmed the strong effect of CHG on Gram-positive bacteria, even at low concentrations (0.05%), whereas the efficacy against Gram-negative bacteria was worse. The greatest disinfection effectiveness was recorded for the highest concentration (0.5%), regardless of the evaluated microbe strain. However, no difference in efficacy between the 0.2% and 0.12% concentrations was observed, regardless of the bacterial strain assessed. Other authors report similar results. Leshem et al. demonstrated that CHG had low effectiveness against P. aeruginosa obtained from skin injuries.37 In their study, the minimum inhibitory concentration (MIC) for this strain was 1,024 µg/mL,37 although in the works of other authors, the efficacy of solutions of 8–10 μg/mL was reported.38, 39, 40 Mengistu et al. presented only a minimal disinfecting effect of 0.05% CHG solution against many bacterial strains, such as Actinobacter, Klebsiella pneumonia, Enterobacter, Pseudomonas, and Proteus.41
It was also shown in the present study that all tested Candida strains were sensitive to CHG, even at the lowest analyzed concentration. Their vulnerability was significantly higher than that of the Gram-positive bacteria, but comparable to that of the Gram-negative bacterium. It was proved that CHX impairs the yeast cell wall through binding with cell wall beta-glucan, causing temporary or permanent damage, depending on the concentration.42 The highest studied concentration worked the best, just like in the case of bacteria. However, no difference was noted between the 0.2% and 0.12% concentrations, regardless of the yeast strain assessed. Another study using the MTT test showed a high effectiveness of 0.2% CHG against the Candida strains, with the viability of fungal cells decreasing along with an increase in the application time of the disinfectant.43
Furthermore, it was shown that the antifungal properties of CHX against C. albicans were stronger as compared to some polyene antibiotics, such as nystatin or amphotericin B.5, 44 It should be remembered that in complex candidiasis treatment, CHX and nystatin should not be used together, since they induce a pharmacological interaction responsible for the reduction of their efficacy.45, 46 Nevertheless, positive interactions between miconazole and CHX have been proven, enabling the simultaneous use of these agents during the local therapy of oral candidiasis.47 Beneficial effects have also been observed for the topical use of CHX combined with fluconazole; such a regimen decreases the mass and growth of Candida single-strain biofilm.48
The second stage of the study investigated the disinfecting properties of 5 combined preparations containing 0.2% CHG solution and different supplements added to facilitate the symptomatic treatment of infections through several different mechanisms of action (anti-inflammatory, analgesic, local anesthetic, tissue healing acceleration, blood vessel sealing, and stengthening natural immune mechanisms). This part of the experiment was based on the knowledge that combined preparations, apart from the expected drug-specific reactions, sometimes show qualitative and quantitative deviations in their activity. These phenomena include the synergism and antagonism of action. Synergism is a phenomenon in which individual ingredients support each other, boosting the pharmacological effects. The effect of such an interaction is either the addition (additive synergism) or potentiation of action (super-additive synergism) of simultaneously used substances. Antagonism involves inhibiting or eliminating the pharmacological effects of simultaneously used ingredients. There are 3 types of antagonism distinguished: competitive (when the substances compete for the same receptor); functional (when the substances have an adverse mechanism of action); and chemical (when the substances react with each other and create a weaker or biologically inactive compound).
Given the cationic structure of the molecule, numerous antagonist actions of CHG with the compounds containing organic anions (detergents, natural soaps) and inorganic anions (nitrates, chlorides, phosphates, carbonates, and sulfates) are known. In such cases, ionic inactivation and salt precipitation occur. Also, alginates, carboxymethylcellulose and tragacanth can inactivate CHG, mainly through the absorption mechanism.5 Combining CHX and sodium hypochlorite causes the precipitation of a flocculent sediment containing insoluble magnesium (Mg), iron (Fe) and calcium (Ca) salts, and the precipitate parachloroaniline (PCA).49, 50 Similar antagonistic mechanisms of action exhibit CHX and ethylenediaminetetraacetic acid (EDTA); their interaction produces pink inactive precipitates.51 It has also been shown that most of non-ionic surfactants significantly decrease the effectiveness of CHX.5
What is also of great importance for the activity of CHX is the pH of the substance and the environment in which the substance is used. The most stable are the aqueous solutions of CHG with pH ranging from 5 to 8, whereas the most beneficial environmental pH is from 5.5 to 7, corresponding to the pH of the oral cavity.52 A well-examined substance increasing the antimicrobial properties of CHG is diethyl alcohol, which is why it is often added in small amounts to commercially available products.53, 54 However, none of the preparations analyzed in our experiment contained this additive. Nevertheless, all of the tested combined preparations showed good disinfecting properties against bacteria and yeasts.
Similar to the results obtained by other authors and in the first part of our study, the second phase of our experiment confirmed greater efficacy of CHG in combined preparations against Gram-positive bacteria than against Gram-negative microorganisms. The preparations presented the strongest effect against streptococcus, and slightly weaker against staphylococcus and cocci. Alansari et al. demonstrated strong antibacterial activity of CHX-loaded halloysite nanotubes against S. aureus, Streptococcus pneumoniae and Streptococcus agalactioe on acrylic plates.55 Manuschai et al. showed great effectiveness of 1% and 2% CHG solutions in eliminating the dual-species biofilm of C. albicans and Streptococcus mutans.56 The effective biocidal action of CHG against Gram-positive bacteria results from the electrical charge of the cell wall of these microorganisms. It has a much higher negative charge in comparison with Gram-negative bacteria, so the strength of the interaction is greater.5 Thus, the MICs for these bacteria are less than 10 µg mL; for Gram-negative bacteria, the values are more variable and seldom below 50 µg/mL.48, 49 Some Gram-negative microbes, e.g., Mycobacterium tuberculosis, are insensitive to CHX action.53, 54 In our study, the effect of the CHG + colostrum preparation against S. aureus ATCC 43300 was noteworthy (33.06 mm) and indicated strong additive synergism. In this case, the GIZ was more than double that of the 2nd most potent combined preparation – CHG + chamomile extract (16.47 mm for S. pyogenes). All other combination formulations tested showed disinfecting potency similar to that of the simple 0.02% CHG formulation (the positive control group of this study) against each of the evaluated bacterial strains. None of the combined preparations had an action statistically significantly weaker than the positive control. Silva et al. compared the effectiveness of 3 plant-derived compounds in combination with CHX.30 They showed, in contrast to our study, significant enhancement of the antibacterial activity of all their combinations, as indicated by reduced MIC values.30 Hegde and Kamath demonstrated greater efficacy of a 0.12% CHX mouth rinse as compared to a combination (CHX and sodium fluoride) mouth rinse and a green tea extract (0.5%) mouth rinse in reducing the salivary count of S. mutans and Lactobacillus, with the latter two being similar in terms of efficacy.57
When evaluating the efficacy of CHX combined formulations against yeasts, their lower antimicrobial activity, comparable to that in the case of P. aeruginosa ATCC 27853, is noteworthy. None of the assessed rinses showed exceptionally greater activity, and only in the case of C. krusei were the values of all tested preparations statistically significantly higher than for the positive control. On the other hand, it should also be noted that for the C. glabrata and C. parapsilosis strains, none of the rinses showed statistically significantly lower efficacy. The study results obtained by Korbecka-Paczkowska and Karpiński, who assessed the antifungal activity of 15 different commercial oral rinses against 12 strains of Candida spp., showed a good disinfecting effect and a moderate antibiofilm effect of 0.12% CHG and CHG with CPC.58 Statistically significant differences were noted between the rinses. The rinse with octenidine dihydrochloride had the strongest effect against Candida spp.58 Also, a study by Fathilah et al. confirmed good efficacy of CHX and CPC against Candida tropicalis and C. krusei.59 In this study, the combination of CHX and CPC doubled the inhibitory effect against Candida spp. expressed by MIC.59 Handschuh Briones et al. assessed the efficacy of 6 oral rinses, including two 0.1% and 0.12% CHX solutions, and 2 CHX solutions with CPC, against 10 strains of Candida spp. and other yeasts (Rhodotorula).60 All tested preparations achieved a good disinfecting effect. Contrary to the results of Fathilah et al.,59 there were no statistically significant differences in the effect of CHX with CPC as compared to CHX alone.60
In the future, we would like to expand the study to include wild-type strains obtained from the oral swabs of patients presenting with various forms of oral candidiasis and impetigo. This would allow us to confront the obtained laboratory results with clinical needs, and to prepare guidelines and procedures for the pharmacological management of these difficult, chronic and recurrent oral diseases.
In conclusion, it should be noted that the analyzed combined preparations proved good disinfecting properties against bacteria and yeasts. Preparing commercial dental rinses with additives affecting various elements of symptomatic treatment and exhibiting an anti-causative effect did not result in the loss of pharmacological efficacy of CHG and allows a comprehensive treatment effect to be achieved. Using a combined preparation will also limit the patient’s purchases to only one product, saving money. The large range of products offered enables the patient to choose the rinse best suited to their therapeutic needs, depending on the predominant clinical symptoms (pain, swelling, irritation). Often, the additives used also favorably alter the taste of the mouthwash (CHX is a relatively bitter substance), ensuring greater willingness on the part of the patient to maintain the prescribed therapeutic regimen.
Conclusions
The evaluated combined preparations of CHG showed disinfecting efficacy against selected bacterial and fungal strains comparable to that of simple formulations. The combination of 0.2% CHG with colostrum showed the additive synergism of antimicrobial activity against the S. aureus ATCC 43300 strain.
Ethics approval and consent to participate
Not applicable.
Data availability
The datasets supporting the findings of the current study are available from the corresponding author on reasonable request.
Consent for publication
Not applicable.
Use of AI and AI-assisted technologies
Not applicable.